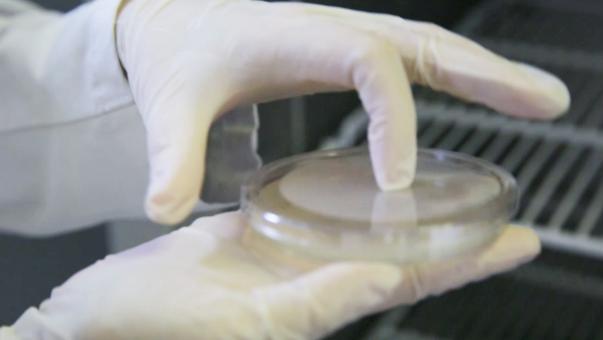

- +1
原来临床用血有这么多要求!你看的影视剧穿帮了没?
红色的血液缓缓流入大出血的病人体内
随后医生宣布病人暂时脱离危险
 观看影视作品时,你会不会好奇:
观看影视作品时,你会不会好奇:血液救治的效果这么好
那血液在医院是如何储存和输注的呢?
医院对血液有哪些管理措施?
快戳这个视频解惑吧↓
视频知识点太多?
精简文字版也为你整理好啦↓
医疗机构临床用血的
主要法律法规和标准
✦《中华人民共和国献血法》
✦《医疗机构临床用血管理办法》
✦《临床输血技术规范》
✦《血液储存要求(WS399-2012)》
血液来源及储存要求
✦医疗机构应当使用卫生行政部门指定血站提供的血液。
✦血液入库前输血部门应对运输条件、物理外观、血袋封闭及包装、标签填写等内容核对验收。
✦贮血冰箱应使用专用冰箱,冰箱内严禁存放其他物品。
✦按A、B、O、AB血型将全血、血液成分分别贮存于血库专用冰箱不同层内或不同专用冰箱内,并有明显标识。
✦血液储存设备应有可视温度显示,储血保管人员应当做好血液储藏温度的24小时监测记录。
✦贮血冰箱应每周消毒一次,冰箱内空气培养每月一次。

临床用血相关文书要求
临床用血相关文书要求医疗机构应当确保临床用血信息客观真实、完整、可追溯。规范的输血医疗文书应全面记录患者输血前的情况到输血结束后的评估过程。
临床输血申请单:由具有中级以上专业技术职务任职资格的医师提出申请,根据同一患者一天申请备血量的不同,应由不同级别的医师或医务部门核准签发后备血。
输血治疗知情同意书:在输血治疗前,医师应当向患者或者其近亲属说明输血目的、方式和风险,并签署《输血治疗知情同意书》。
医师应当将患者输血适应证的评估、输血过程和输血后疗效评价情况记入病历;临床输血治疗知情同意书、输血记录单等随病历保存。有输血反应的,还应填写患者输血反应回报单。
 温
温馨
提
醒
为保障输血安全及有效,医疗机构应当做好临床用血的组织管理、制度建设、血液储存及相关文书管理工作,依据《中华人民共和国献血法》《医疗机构临床用血管理办法》等规定,医疗机构或个人违反有关规定的,将面临警告或罚款的行政处罚,构成犯罪的,将依法追究刑事责任。
来源:浦东卫监

原标题:《原来临床用血有这么多要求!你看的影视剧穿帮了没?》
本文为澎湃号作者或机构在澎湃新闻上传并发布,仅代表该作者或机构观点,不代表澎湃新闻的观点或立场,澎湃新闻仅提供信息发布平台。申请澎湃号请用电脑访问http://renzheng.thepaper.cn。





- 报料热线: 021-962866
- 报料邮箱: news@thepaper.cn
互联网新闻信息服务许可证:31120170006
增值电信业务经营许可证:沪B2-2017116
© 2014-2026 上海东方报业有限公司




